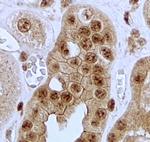
Jagged1 Antibody in Immunohistochemistry (Paraffin) (IHC (P))

Search
Invitrogen
Jagged1 Polyclonal Antibody
{{$productOrderCtrl.translations['antibody.pdp.commerceCard.promotion.promotions']}}
{{$productOrderCtrl.translations['antibody.pdp.commerceCard.promotion.viewpromo']}}
{{$productOrderCtrl.translations['antibody.pdp.commerceCard.promotion.promocode']}}: {{promo.promoCode}} {{promo.promoTitle}} {{promo.promoDescription}}. {{$productOrderCtrl.translations['antibody.pdp.commerceCard.promotion.learnmore']}}
图: 1 / 3
Jagged1 Antibody (PA5-142757) in ICC/IF

产品信息
PA5-142757
种属反应
宿主/亚型
分类
类型
抗原
偶联物
形式
浓度
规格
纯化类型
保存液
内含物
保存条件
运输条件
RRID
产品详细信息
This antibody is tested in Peptide ELISA: antibody detection limit dilution 1:8,000.
靶标信息
The jagged 1 protein encoded by JAG1 is the human homolog of the Drosophilia jagged protein. Human jagged 1 is the ligand for the receptor notch 1, the latter a human homolog of the Drosophilia jagged receptor notch. Mutations that alter the jagged 1 protein cause Alagille syndrome. Jagged 1 signalling through notch 1 has also been shown to play a role in hematopoiesis.
仅用于科研。不用于诊断过程。未经明确授权不得转售。
篇参考文献 (0)
生物信息学
蛋白别名: CD339; jagged canonical Notch ligand 1; Jagged1; Protein jagged-1; putative; Serrate-1; unnamed protein product
基因别名: ABE2; AGS; AGS1; AHD; AWS; CD339; CMT2HH; DCHE; Gsfabe2; HJ1; Htu; JAG1; JAGL1; Ozz; Ser-1
UniProt ID: (Human) P78504, (Mouse) Q9QXX0
Entrez Gene ID: (Human) 182, (Mouse) 16449




